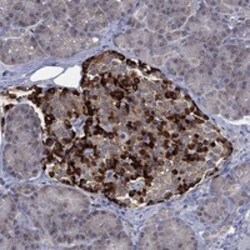
Invitrogen SELENOO Polyclonal Antibody 100 &mu;L; Unconjugated:Antibodies,

Learn More
Invitrogen™ SELENOO Polyclonal Antibody


Rabbit Polyclonal Antibody
Brand: Invitrogen™ PA5140354
Description
Gently mix before use. Optimal concentrations and conditions for each application should be determined by the user. Immunogen sequence: DPDHVCNASD NTGRYAYSKQ PEVCRWNLRK LAEALQPELP LELGEAILAE EFDAEFQRHY LQKMRRKLGL VQVELEEDGA LVSKLLETM Highest antigen sequence indentity to the following orthologs: Rat - 82%, Mouse - 81%.
Catalyzes the transfer of adenosine 5'-monophosphate (AMP) to Ser, Thr and Tyr residues of target proteins (AMPylation) (PubMed:30270044). May be a redox-active mitochondrial selenoprotein which interacts with a redox target protein (PubMed:24751718).
Specifications
| SELENOO | |
| Polyclonal | |
| Unconjugated | |
| SELENOO | |
| Protein Adenylyltransferase SelO, Mitochondrial; Selenoprotein O; selo | |
| Rabbit | |
| Antigen affinity chromatography | |
| RUO | |
| 83642 | |
| Store at 4°C short term. For long term storage, store at -20°C, avoiding freeze/thaw cycles. | |
| Liquid |
| Immunohistochemistry (Paraffin) | |
| 0.2 mg/mL | |
| PBS with 40% glycerol and 0.02% sodium azide; pH 7.2 | |
| Q9BVL4 | |
| SELENOO | |
| Recombinant protein corresponding to Human SELENOO. Recombinant protein control fragment (Product #RP-109688). | |
| 100 μL | |
| Primary | |
| Human | |
| Antibody | |
| IgG |
Your input is important to us. Please complete this form to provide feedback related to the content on this product.